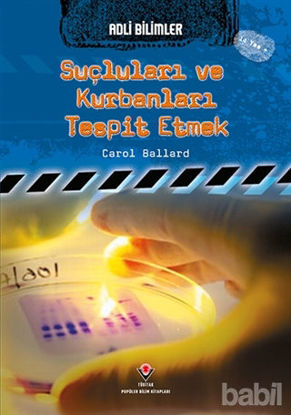
Picture of Adli Bilimler : Suçluları ve Kurbanları Tespit Etmek

You have no items in your shopping cart.
- Çocuk Kitapları (17209)
- Bilmece, Bulmaca (898)
- Çıkartmalı Kitaplar (490)
- Diğer (1978)
- Okul Öncesi Çocuk Kitapları (1090)
- Roman-Öykü (4763)
- Çizgi Roman (254)
- Hikayeler (6312)
- Referans Kitaplar (271)
- Boyama Kitapları (631)
- Hobi-Müzik (256)
- Oyun Kitapları (309)
- Okul Öncesi Şekilli Kitaplar (115)
- Zeka Gelişimi (426)
- Masallar (1632)
- Şiir Kitapları (167)
- Din Eğitimi (438)
- Dünya Klasikleri (257)
- Türk Klasikleri (12)
- Bilimsel Kitaplar (604)
- Yapbozlu Kitaplar (7)
- Hobi (1304)
- Edebiyat (39354)
- Çizgi Roman (1607)
- Şiir (6091)
- Deneme (2985)
- Araştırma-İnceleme-Referans (1329)
- Türk Edebiyatı (6239)
- Biyografi-Otobiyografi (1398)
- Senaryo (806)
- Roman (11412)
- İngiliz Edebiyatı (453)
- Divan Edebiyatı - Halk Edebiyatı (341)
- Bilimkurgu (346)
- Alman Edebiyatı (258)
- Tarihsel Romanlar (1036)
- Anı - Mektup - Günlük (1877)
- Aksiyon - Macera (426)
- Öykü (3575)
- Polisiye (816)
- Derleme (110)
- Eleştiri, İnceleme, Kuram (556)
- Amerikan Edebiyatı (639)
- İtalyan Edebiyatı (92)
- Diğer Ülke Edebiyatları (535)
- Antoloji (227)
- Rus Edebiyatı (465)
- Aşk (645)
- Korku-Gerilim (385)
- Anlatı (466)
- Politik Kurgu (79)
- Fransız Edebiyatı (431)
- Kürt Edebiyatı (514)
- Latin Edebiyatı (67)
- Mizah (456)
- Dil Bilim (169)
- Fantastik (748)
- Efsane-Destan (195)
- Ortadoğu - Arap Edebiyatı (111)
- Klasikler (673)
- Uzakdoğu Edebiyatı (55)
- Oyun (273)
- Karikatür (121)
- İskandinav Edebiyatı (20)
- Periyodik Yayınlar (13)
- İspanyol Edebiyatı (74)
- Gençlik Edebiyatı (454)
- Söyleşi (123)
- Seyahatname (45)
- Genel Konular (8814)
- Sanat (2164)
- Felsefe (3610)
- Müzik (559)
- Akademik (5826)
- İnsan ve Toplum (5295)
- Ekonomi (3545)
- İşletme, Muhasebe, Maliye (908)
- Halkla İlişkiler, İnsan Kaynakları (554)
- İş Dünyası (764)
- Türkiye Ekonomisi (363)
- Araştırma-İnceleme-Kuram (610)
- Dünya Ekonomisi (313)
- Borsa - Finans (281)
- Küreselleşme (33)
- Yönetim (443)
- Diğer (593)
- Referans Kitaplar (50)
- Pazarlama, Satış, Reklam (236)
- E-Ticaret (38)
- Hukuk (2703)
- Bilim - Mühendislik (1570)
- Popüler Bilim (380)
- Doğa Bilimleri (79)
- Tıp Bilimleri (243)
- Bilim Tarihi (121)
- Diğer (376)
- Matematik - Geometri (98)
- Nükleer Enerji Mühendisliği (2)
- Bilgisayar Mühendisliği (7)
- İnşaat Mühendisliği (28)
- Elektrik-Elektronik Mühendisliği (19)
- Makine Mühendisliği (19)
- Astronomi - Fizik (34)
- Mimarlık (48)
- Kimya (10)
- Sosyal Bilimler (84)
- Psikoloji (1472)
- Periyodik Yayınlar (2054)
- Gezi ve Rehber Kitapları (835)
- Yemek Kitapları (357)
- Bilgisayar (558)
- Microsoft Office (59)
- Bilgisayar Öğrenimi (20)
- Diğer (92)
- Programlama (234)
- İnternet ve İnternet Kültürü (49)
- İşletim Sistemleri (21)
- Grafik ve Tasarım (88)
- Web Geliştirme ve Tasarım (84)
- Veritabanı - Database (16)
- Ağ - Networking (17)
- Bilgisayar Teknolojisi (36)
- Donanım - Hardware (2)
- Güvenlik - Security (10)
Categories
- Çocuk Kitapları (17209)
- Bilmece, Bulmaca (898)
- Çıkartmalı Kitaplar (490)
- Diğer (1978)
- Okul Öncesi Çocuk Kitapları (1090)
- Roman-Öykü (4763)
- Çizgi Roman (254)
- Hikayeler (6312)
- Referans Kitaplar (271)
- Boyama Kitapları (631)
- Hobi-Müzik (256)
- Oyun Kitapları (309)
- Okul Öncesi Şekilli Kitaplar (115)
- Zeka Gelişimi (426)
- Masallar (1632)
- Şiir Kitapları (167)
- Din Eğitimi (438)
- Dünya Klasikleri (257)
- Türk Klasikleri (12)
- Bilimsel Kitaplar (604)
- Yapbozlu Kitaplar (7)
- Hobi (1304)
- Edebiyat (39354)
- Çizgi Roman (1607)
- Şiir (6091)
- Deneme (2985)
- Araştırma-İnceleme-Referans (1329)
- Türk Edebiyatı (6239)
- Biyografi-Otobiyografi (1398)
- Senaryo (806)
- Roman (11412)
- İngiliz Edebiyatı (453)
- Divan Edebiyatı - Halk Edebiyatı (341)
- Bilimkurgu (346)
- Alman Edebiyatı (258)
- Tarihsel Romanlar (1036)
- Anı - Mektup - Günlük (1877)
- Aksiyon - Macera (426)
- Öykü (3575)
- Polisiye (816)
- Derleme (110)
- Eleştiri, İnceleme, Kuram (556)
- Amerikan Edebiyatı (639)
- İtalyan Edebiyatı (92)
- Diğer Ülke Edebiyatları (535)
- Antoloji (227)
- Rus Edebiyatı (465)
- Aşk (645)
- Korku-Gerilim (385)
- Anlatı (466)
- Politik Kurgu (79)
- Fransız Edebiyatı (431)
- Kürt Edebiyatı (514)
- Latin Edebiyatı (67)
- Mizah (456)
- Dil Bilim (169)
- Fantastik (748)
- Efsane-Destan (195)
- Ortadoğu - Arap Edebiyatı (111)
- Klasikler (673)
- Uzakdoğu Edebiyatı (55)
- Oyun (273)
- Karikatür (121)
- İskandinav Edebiyatı (20)
- Periyodik Yayınlar (13)
- İspanyol Edebiyatı (74)
- Gençlik Edebiyatı (454)
- Söyleşi (123)
- Seyahatname (45)
- Genel Konular (8814)
- Sanat (2164)
- Tarih (8564)
- Politika Siyaset (6029)
- Dünya Siyaseti ve Politikası (1401)
- Uluslararası İlişkiler, Dış Politika (885)
- Diğer (1852)
- Siyaset Bilimi (602)
- Avrupa Birliği (281)
- Azınlıklar, Etnik Sorunlar (740)
- Genel Politika, Siyaset Bilim, Siyaset Tarihi (1173)
- İslam, Ortadoğu (265)
- Kurumlar, Örgütler (369)
- Derin Siyaset, Komplo Teorileri (270)
- Sol Hareketler (568)
- Türkiye Siyaseti ve Politikası (1093)
- Araştırma-İnceleme (987)
- Politik Akımlar - Hareketler (1144)
- Güncel Siyaset (99)
- İslam (9447)
- İslam ve Günümüz İslam Düşüncesi (643)
- Tasavvuf - Mezhepler - Tarikatlar (1753)
- Diğer (3219)
- İslam Tarihi (595)
- Kuran ve Kuran Üzerine (1643)
- Araştırma-İnceleme (1538)
- Biyografi - Otobiyografi (605)
- Edebiyat - Roman (665)
- İslam Eğitimi (910)
- Aile ve Çocuk (3)
- İslam Hukuku (131)
- Alevilik-Bektaşilik (292)
- Meal-Tefsir-Hadis (375)
- İman Esasları (24)
- Felsefe (3610)
- Müzik (559)
- Eğitim (5735)
- Akademik (5826)
- Sosyoloji (2605)
- İnsan ve Toplum (5295)
- Ekonomi (3545)
- İşletme, Muhasebe, Maliye (908)
- Halkla İlişkiler, İnsan Kaynakları (554)
- İş Dünyası (764)
- Türkiye Ekonomisi (363)
- Araştırma-İnceleme-Kuram (610)
- Dünya Ekonomisi (313)
- Borsa - Finans (281)
- Küreselleşme (33)
- Yönetim (443)
- Diğer (593)
- Referans Kitaplar (50)
- Pazarlama, Satış, Reklam (236)
- E-Ticaret (38)
- Hukuk (2703)
- İnanç Kitapları - Mitolojiler (1168)
- Bilim - Mühendislik (1570)
- Popüler Bilim (380)
- Doğa Bilimleri (79)
- Tıp Bilimleri (243)
- Bilim Tarihi (121)
- Diğer (376)
- Matematik - Geometri (98)
- Nükleer Enerji Mühendisliği (2)
- Bilgisayar Mühendisliği (7)
- İnşaat Mühendisliği (28)
- Elektrik-Elektronik Mühendisliği (19)
- Makine Mühendisliği (19)
- Astronomi - Fizik (34)
- Mimarlık (48)
- Kimya (10)
- Sosyal Bilimler (84)
- Psikoloji (1472)
- Yabancı Dilde Kitaplar (2240)
- Sağlık (1399)
- Periyodik Yayınlar (2054)
- Gezi ve Rehber Kitapları (835)
- Yemek Kitapları (357)
- Bilgisayar (558)
- Microsoft Office (59)
- Bilgisayar Öğrenimi (20)
- Diğer (92)
- Programlama (234)
- İnternet ve İnternet Kültürü (49)
- İşletim Sistemleri (21)
- Grafik ve Tasarım (88)
- Web Geliştirme ve Tasarım (84)
- Veritabanı - Database (16)
- Ağ - Networking (17)
- Bilgisayar Teknolojisi (36)
- Donanım - Hardware (2)
- Güvenlik - Security (10)
- Genel (0)
- Güncellenecek (0)
- GÜNCELLENECEK (0)
- Kırtasiye (0)
- Hizmet (7)
- Oyun - Oyuncak (0)
- Electronics (9)
- Apparel (10)
- Digital downloads (3)
- Books (3)
- Jewelry (3)
- Gift Cards (3)
Price
-
Category
- Çocuk Kitapları 55
- Bilimsel Kitaplar 42
- Bilim - Mühendislik 20
- Popüler Bilim 11
- Hikayeler 7
- Genel Konular 7
- Başvuru Kitapları 7
- Akademik 6
- Diğer 6
- Diğer 5
- Hobi 4
- Bilmeceler, Bulmacalar 4
- Bilmece, Bulmaca 3
- Tıp Bilimleri 2
- Okul Öncesi Çocuk Kitapları 1
- Referans Kitaplar 1
- Hobi-Müzik 1
- Oyun Kitapları 1
- Bilim Tarihi 1
Writers
Basım ülkesi adı
- Türkiye 81
Cep boy olup olmadığı bilgisi
- False 81
Ürün formatı adı
- Kitap 81
Boy bilgisi (cm)
En bilgisi (cm)
Sayfa sayısı
Ağırlık bilgisi (gram)
- 160,00 9
- 180,00 7
- 100,00 6
- 270,00 4
- 450,00 4
- 200,00 4
- 171,00 3
- 72,00 3
- 24,00 3
- 128,00 2
- 32,00 2
- 102,00 2
- 96,00 2
- 327,00 1
- 120,00 1
- 690,00 1
- 114,00 1
- 273,00 1
- 357,00 1
- 125,00 1
- 151,00 1
- 341,00 1
- 277,00 1
- 616,00 1
- 300,00 1
- 302,00 1
- 252,00 1
- 192,00 1
- 45,00 1
- 356,00 1
- 90,00 1
- 176,00 1
- 812,00 1
- 250,00 1
- 101,00 1
- 230,00 1
- 159,00 1
- 698,00 1
- 30,00 1
- 26,00 1
- 903,00 1
- 521,00 1
- 49,00 1
Categories
- Çocuk Kitapları (17209)
- Hobi (1304)
- Edebiyat (39354)
- Genel Konular (8814)
- Sanat (2164)
- Tarih (8564)
- Politika Siyaset (6029)
- İslam (9447)
- Felsefe (3610)
- Müzik (559)
- Eğitim (5735)
- Akademik (5826)
- Sosyoloji (2605)
- İnsan ve Toplum (5295)
- Ekonomi (3545)
- Hukuk (2703)
- İnanç Kitapları - Mitolojiler (1168)
- Bilim - Mühendislik (1570)
- Psikoloji (1472)
- Yabancı Dilde Kitaplar (2240)
- Sağlık (1399)
- Periyodik Yayınlar (2054)
- Gezi ve Rehber Kitapları (835)
- Yemek Kitapları (357)
- Bilgisayar (558)
- Genel (0)
- Güncellenecek (0)
- GÜNCELLENECEK (0)
- Kırtasiye (0)
- Hizmet (7)
- Oyun - Oyuncak (0)
- Electronics (9)
- Apparel (10)
- Digital downloads (3)
- Books (3)
- Jewelry (3)
- Gift Cards (3)
Yayınevi
Recently viewed products
TÜBİTAK Yayınları
Customer service
Copyright © 2026 Your store name. All rights reserved.
Powered by nopCommerce